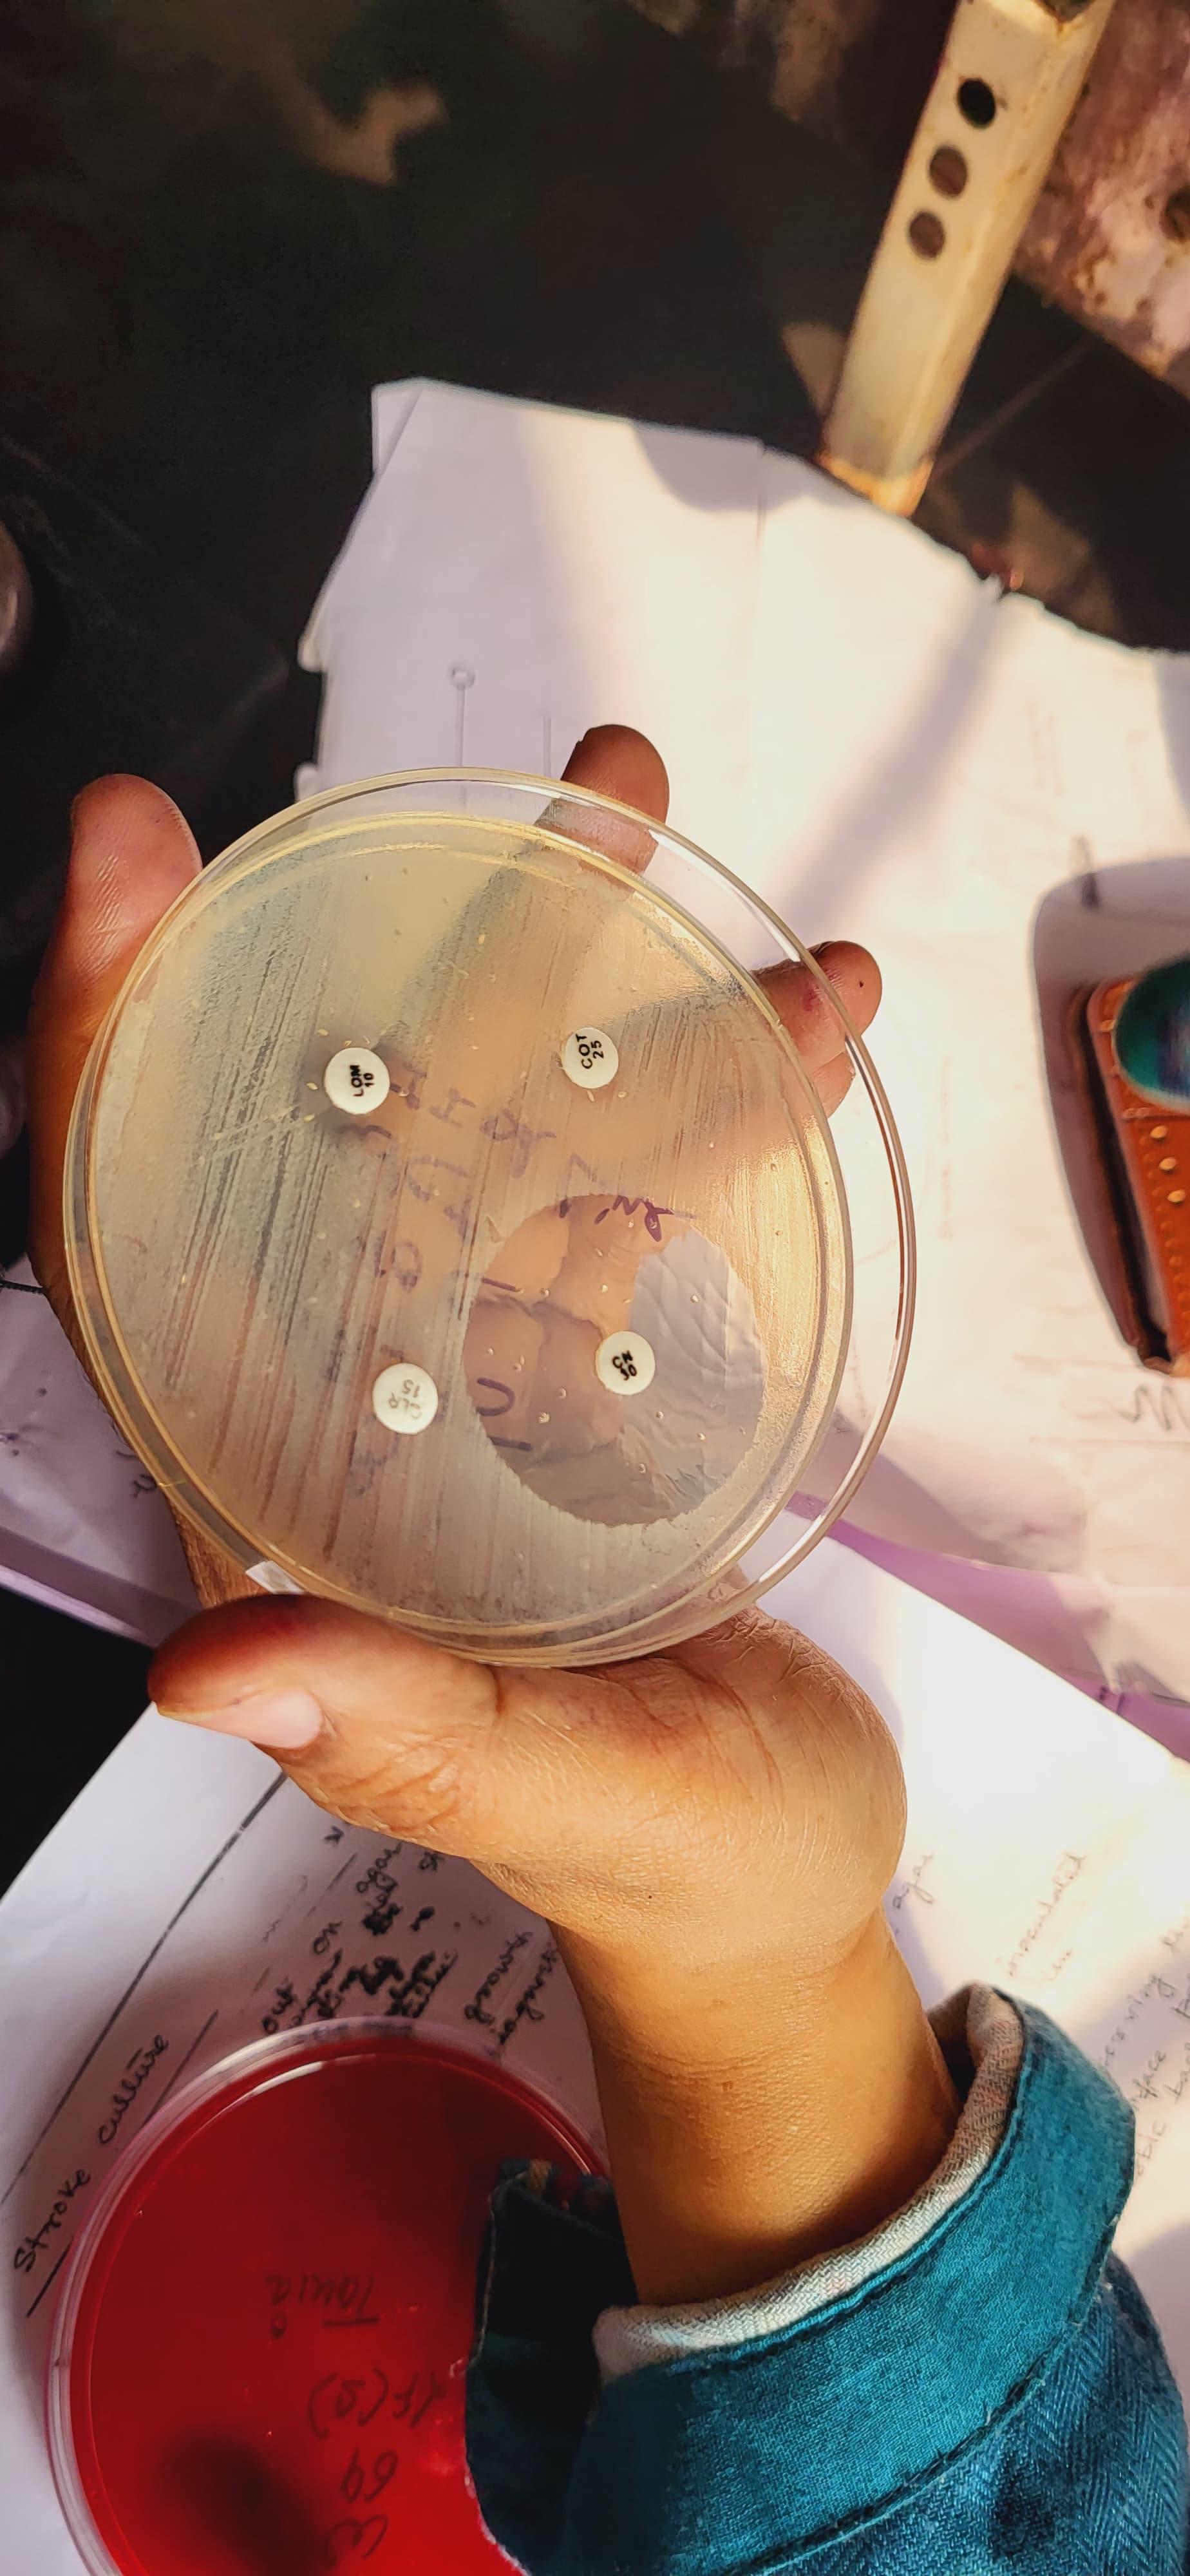

RG Kar Medical College and Hospital, often referred to as RGKMC, is an esteemed government medical school located in Kolkata, West Bengal. Founded in 1886, it is among India's oldest and most respected medical schools of India. The institution has been approved by the National Medical Commission (NMC) and is affiliated with the West Bengal University of Health Sciences (WBUHS).
RG Kar Kolkata has a long history of providing excellent medical education, research, and patient care. It is a key part of healthcare in Eastern India. India Today put it at #22 in medical colleges, IIRF put it at #38, and Collegedunia put it at #205.
RG Kar Kolkata offers a wide range of academic programs, including MBBS, MD/MS, and Diploma courses in a number of medical fields. The flagship program is MBBS and other postgraduate programs include MD in General Medicine, Pathology, Psychiatry, and Radiology, as well as MS in General Surgery, Obstetrics and Gynecology, and Orthopedics. There are also M.Ch, M.Sc., and Diploma programs at the college in a number of specializations. The entrance exam for admission to RGKMC is NEET-UG for MBBS and the NEET-PG for MD/MS.
Table of Contents
- RG Kar Kolkata Highlights 2025
- RG Kar Kolkata Important Dates 2025
- RG Kar Kolkata Ranking 2025
- RG Kar Kolkata Courses and Fees 2025
- RG Kar Kolkata Admission 2025
- RG Kar Kolkata Cutoff 2025
- RG Kar Kolkata Placement 2025
- RG Kar Kolkata Scholarships 2025
- RG Kar Kolkata vs IPGMER Kolkata
- RG Kar Kolkata Campus and Facilities 2025
- RG Kar Kolkata Alumni
- RG Kar Kolkata FAQs
RG Kar Kolkata Highlights 2025
Here are the key highlights of RGKMCH:
| Particulars | Details |
|---|---|
| Name | R.G. Kar Medical College and Hospital (RG Kar Kolkata) |
| Established | Type | 1886 | Government |
| Location | Kolkata, West Bengal |
| Approved By | National Medical Commission (NMC) |
| Affiliated To | West Bengal University of Health Sciences (WBUHS) |
| Courses Offered | Flagship: MBBSOthers: MD, MS, Diploma |
| Application Mode | Online (via WBUHS/NEET Counseling) |
| Eligibility Criteria | MBBS: NEET-UGMD/MS: NEET-PGM.Ch: NEET PG |
| Top Recruiters / Placements | Government Hospitals (AIIMS, SSKM, CNMC), State Health Services, Private Hospitals, Research Institutions |
| Placement Rate | High in Government Sector (Medical Officer, Resident Doctor Roles) |
| Official Website | rgkar.edu.in |

RG Kar Kolkata Overview
RG Kar Kolkata Important Dates 2025
Admissions are open for MBBS and MD/MS programs at RG Kar Kolkata. Key dates for entrance exam-based admissions are as follows:
RG Kar Kolkata MBBS Important Dates 2025
Admission to the MBBS program is based on NEET-UG 2025:
| Events | Dates |
|---|---|
| NEET-UG 2025 Exam | May 4, 2025 |
| NEET-UG Result Declaration | June 14, 2025 |
| Registration On DME Portal | July 21 - July 29, 2025 |
| Choice Filling & Locking | July 31 - August 4, 2025 |
| Round 1 Seat Result | August 6, 2025 |
| Reporting at Allotted College | August 7 – August 11, 2025 |
| Upgrade Option and Second round registration | August 7 - August 16, 2025 |
RG Kar Kolkata MD/MS Important Dates 2025
Admission to MD/MS programs is based on the NEET-PG 2025 results.
| Events | Dates |
|---|---|
| NEET-PG 2025 Application | April 17, 2025 |
| NEET-PG Admit Card | July 31, 2025 |
| NEET PG Exam | August 3, 2025 |
| NEET PG Result | September 3, 2025 |
| NEET PG Counselling | Late September 2025 |
RG Kar Kolkata Ranking 2025
R.G. Kar Medical College and Hospital holds a strong reputation in the medical education landscape of India. Within West Bengal, it ranks among the top 10 MBBS colleges, reflecting its consistent academic performance and clinical excellence.
Here are RG Kar Kolkata Ranking through different ranking agencies:
| Ranking Agency | Category | Year | Rank/Position |
|---|---|---|---|
| Medical | 2019 | #22 | |
| Medical | 2025 | 205 | |
| Medical | 2024 | #38 |
RG Kar Kolkata Courses and Fees 2025
RG Kar Kolkata offers undergraduate and graduate medical programs with a focus on clinical training, academic excellence, and practical hospital experience. Its flagship course is MBBS. The MBBS program lasts for 5.5 years and includes an internship. The seat intake for MBBS is 250 students. The tuition fee is very low because it is a government medical college. The first year costs ₹6,500, and from the second year on, it costs ₹9,000 a year, for a total of about ₹42,500. For postgraduate medical education, the college also offers MD/MS programs in 19 specialties, such as General Medicine, Pediatrics, Obstetrics & Gynaecology, Pathology, Microbiology, and others.
While the tuition is minimal, other charges like hostel, mess, exam fees, and university registration are billed separately. The college allows flexible fee payment options, including annual and semester-wise payment modes.
Tabulated below are the important details about RG Kar Kolkata courses and fees, along with duration. The fees mentioned are tuition fees only; additional charges such as hostel and mess fees are separate.
| Course | Total Fees | Duration |
|---|---|---|
| MBBS | INR 42,500 | 5.5 Years |
| M.D/M.S | INR 36,000 | 3 Years |
| M.Ch | INR 36,000 | 3 Years |
| M.Sc | INR 24,000 | 2 Years |
RG Kar Kolkata Admission 2025
Students are admitted to RG Kar Kolkata's MBBS, MD/MS, diploma, and super-specialty programs according to their NEET scores. The Medical Counselling Committee (MCC) handles centralized counseling for All India Quota (AIQ) and NRI seats, while the West Bengal Medical Counselling Committee (WBMCC) handles it for state quota seats. Eligible candidates must register and apply online via the official counselling portals within the prescribed schedule.
Tabulated below are RG Kar Kolkata Admissions to some of the courses with their eligibility criteria and admission process.
| Program | Eligibility Criteria | Admission Process |
|---|---|---|
| MBBS | 10+2 with PCB (50% for Gen/OBC, 40% for SC/ST) | NEET-UG + WBMCC / MCC Counseling |
| MD / MS | MBBS degree with internship completion | NEET-PG + WBMCC / MCC Counseling |
| Diploma | MBBS degree | NEET-PG + WBMCC / MCC Counseling |
| DM / M.Ch | MD/MS in relevant discipline | NEET-SS + MCC Counseling |
RG Kar Kolkata Cutoff 2025
RG Kar Kolkata Cutoff 2025 has not been released yet. The category-wise cutoff for admission depends on NEET scores and changes every year. Candidates can refer to the previous years’ RG Kar Kolkata Cutoff for an idea about the cutoff trends.
RG Kar Kolkata NEET UG Cutoff 2025 (All-India Quota)
RG Kar Kolkata offers admission in MBBS courses through NEET. From the NEET UG 2024 cutoff, Students can get a brief idea of how much cutoff is required to get admission in RG Kar Kolkata.
| Category | Round 1 | Round 2 | Round 3 | Round 4 |
|---|---|---|---|---|
| General | 7437 | 12461 | 13631 | 15973 |
| OBC | 8061 | 12928 | 15074 | 17873 |
| SC | 48498 | 87902 | 99260 | NA |
| ST | 99342 | 116228 | 124137 | NA |
| EWS | 9196 | 13301 | 15673 | NA |
RG Kar Kolkata NEET UG Cutoff: Year-Wise Trends
| Category | 2024 | 2023 | 2022 | 2021 | 2020 |
|---|---|---|---|---|---|
| General | 15,973 | 17,058 | 13,054 | 4,986 | 5,706 |
| OBC | 17,873 | 9,355 | 15,268 | 6,138 | NA |
| SC | 99,260 | 79,931 | 1,16,344 | 33,674 | 39,705 |
| ST | 1,24,137 | 1,21,291 | 91,276 | 76,324 | 74,127 |
| EWS | 15,673 | 16,921 | 23,278 | 5,889 | NA |
RG Kar Kolkata NEET PG Cutoff 2025 (All India)
RG Kar Kolkata offers admission in M.D, M.S. courses through NEET-PG. From the 2024 cutoff, Students can get a brief idea of how much cutoff is required to get admission in RG Kar Kolkata.
| Category | Round 1 | Round 2 | Round 3 | Round 4 |
|---|---|---|---|---|
| General | 99813 | 92983 | 161959 | 179632 |
| OBC | 110462 | 52074 | 183477 | 188957 |
| SC | 126190 | 119176 | 189677 | 162859 |
| EWS | 59419 | 90565 | 173242 | NA |
| ST | 92108 | 85523 | 98002 | 97755 |
RG Kar Kolkata Placement 2025
RG Kar Kolkata prepares its MBBS and postgraduate medical graduates ahead in their careers due to its hospital-integrated training model. Even though the college does not have an official corporate-style placement cell, the following outcomes are consistently accomplished:
- Junior Resident Positions: There are many graduates who take up posts as Junior Residents at the college hospital and its affiliate government health centres.
- Government Work: Besides the college, numerous graduates are absorbed in the government’s medical services such as the WB Health Department, ESIC Hospitals, and AIIMS on both state and national levels.
- Internship referrals and direct Junior Resident referrals during the internship are also standard practice for the college in addition to the referred community hospitals and partner institutions.
- Medically associated establishments, like the ICMR, offer students the opportunity to undertake funded projects and training, enabling them to undertake both academic and clinically-focused research.
RG Kar Kolkata graduates are in demand to the top private hospitals like Apollo, Fortis, and Medanta due to the exposure the hospital provides in terms of surgery, emergency medicine, and specialty care because of the hospitals high patient turnover. Established graduates are actively involved professionally in India as well as in the Middle east, UK, and the US, which provides students with an extensive domain of career possibilities.
RG Kar Kolkata Scholarships 2025
The scholarships offered to students are based on the merit and talent of the students. Students may apply for the scholarships at the start of the academic year. The scholarships offered to the students are as follows:
- College / University Merit Scholarships.
- Students belonging to the economically weaker sections may ask for price concessions.
- Merit Primarily based scholarships are also awarded through the university to deserving students.
- Merit & National Scholarships for outstanding students beneath Central & State Govt.
RG Kar Kolkata vs IPGMER Kolkata
Here is a detailed comparison between RG Kar Kolkata (RGKMCH), Kolkata and Institute of Post Graduate Medical Education & Research (IPGMER), Kolkata:
| Parameter | R.G. Kar Medical College & Hospital (RG Kar Kolkata) | Institute of Post Graduate Medical Education & Research (IPGMER) & SSKM Hospital |
|---|---|---|
| Type | Government | Government |
| Established | 1886 | 1957 |
| Affiliation | West Bengal University of Health Sciences (WBUHS) | West Bengal University of Health Sciences (WBUHS) |
| Recognition | National Medical Commission (NMC) | National Medical Commission (NMC) |
| Courses Offered | MBBS, MD/MS, DM/M.Ch | MBBS, MD/MS, DM/M.Ch, Nursing, Paramedical, Allied Health |
| MBBS | 250 | 200 |
| Postgraduate Seats (MD/MS) | ~180 | ~200+ |
| Super-specialty Courses | DM/M.Ch in limited disciplines | Extensive DM/M.Ch programs including Cardiology, Neurology, Gastroenterology, etc. |
| Hospital Beds | ~1,200 + bed tertiary care hospital | 1,700+ beds |
| Patient Footfall | High (mixed urban-rural demographics) | Very High (urban tertiary care & referral cases from across Eastern India) |
| Research Facilities | Developing, some ICMR-recognized labs | Extensive, Multiple dedicated research departments, centers of excellence |
| Special Centers | General medical & surgical departments | Digestive & Liver Disease Institute, Neurosciences, Burn Unit, Cardiac Science Center |
| Admission (MBBS) | Through NEET-UG (All India + State quota) | Through NEET-UG (All India + State quota) |
| Admission (PG/SS) | Through NEET-PG & NEET-SS | Through NEET-PG & NEET-SS |
| Campus Facilities | Historic campus with basic modern infrastructure | Large, urban campus with advanced facilities and research support |
| Alumni Network | Strong state-wide presence | Strong national & international alumni presence |
RG Kar Kolkata Campus and Facilities 2025
RG Kar Kolkata is one of the oldest and most prestigious government medical colleges in India, is located in Shyambazar, Kolkata. The urban campus is integrated with a massive hospital setup, offering students top-notch clinical exposure, excellent infrastructure, and research support. With a legacy of over a century, RG Kar Kolkata blends historic architecture with updated modern medical facilities to support comprehensive medical education.
| Facility | Details |
|---|---|
| Campus | Urban campus spread across multiple blocks, attached to 1,200+ bed hospital |
| Academic Blocks | Multiple lecture theatres, demo rooms, smart classrooms, and department labs |
| Laboratories | Full suite: Anatomy, Physiology, Biochemistry, Pathology, Microbiology, etc. |
| Library | Central medical library with 60,000+ books, e-journals, digital databases |
| Hostels | Separate hostels for UG, PG & interns; Wi-Fi, mess, reading rooms, security |
| Sports & Recreation | Football ground, indoor badminton, TT, chess, gymnasium, cultural events |
| Medical Support | 24x7 emergency care, in-house health services, attached super-specialty care |
| Canteen | Multiple student canteens and staff cafeterias |
| Wi-Fi & IT | Campus-wide Wi-Fi, computer labs, e-resource access through WBUHS, NIC & NMC portals |

College Entrance

Inside the Campus

Classroom

Lab
RG Kar Kolkata Alumni
The R.G. Kar Ex-Students' Association is one of India's oldest alumni associations. It provides financial aid to students in need, hosts guest lectures, encourages research projects, and manages the RG Kar Appeal Fund. Alumni regularly take part in advocacy and mentoring activities, which boosts the school's influence on Indian medical education and healthcare.
| Name | Photo | Designation | Hospital/Organisation/Work |
|---|---|---|---|
| Dr. Bidhan Chandra Roy | Chief Minister | Former chief minister of West Bengal | |
| Dr. Nirmal Kumar Ganguly | Microbiologist and Padma Bhushan awardee | National Institute of Immunology, New Delhi | |
| Dr. Upendranath Brahmachari | Indian scientist and Physician discovered urea stibamine | Brahmachari Research Institute | |
| Dr. Sushovan Banerjee | Indian Physician and Politician | - | |
| Dr Sanjeev Kanoria | Owner and Chairman | Advinia HealthCare |
RG Kar Kolkata FAQs
Ques. Does RG Kar Kolkata provide hostel facilities?
Ans. Yes. RG Kar Kolkata provides affordable dorm accommodations for both male and female students. The rooms have shared amenities and are simple but functional. Dormitories are typically assigned to first-year students.
Ques. What is the campus life and infrastructure at RG Kar Kolkata?
Ans. The RG Medical College campus has a library, laboratories, lecture theaters, and associated hospitals for clinical practice. Students take part in academic, sport, and cultural events. The campus location allows for easy access to the amenities of the city and is located in North Kolkata. Convenient access to a canteen and hostels are available on campus.
Ques. Does RG Kar Kolkata have seat reservations?
Ans. Yes, RG Kar Kolkata complies with the central and West Bengal governments' reservation policies. There are reserved quotas for SC, ST, OBC, EWS, and PwD. The All India Quota fills 15% of the seats. The remainder can be obtained through state counseling in West Bengal.
Ques. What courses are offered at RG Kar Kolkata?
Ans. RG Kar Kolkata provides MD/MS programs in more than 20 specialties in addition to 250 seats for MBBS. Additionally, it offers super-specialty courses like M.Ch. and DM. NEET UG, PG, and SS rankings are the basis for all admissions. It is among the best options in the area for those aspiring to become doctors.
Ques. Is RG Kar Kolkata a government institution?
Ans. Yes, RG Kar Kolkata is a government medical college under the West Bengal state government.It was nationalized in 1958 after being founded in 1886. It is affiliated with the West Bengal University of Health Sciences. The college has received full recognition from the NMC.

![R. G. Kar Medical College and Hospital - [RGKMCH]](https://image-static.collegedunia.com/public/college_data/images/logos/1473168600logonew.png?h=71.7&w=71.7&mode=stretch)

.png?h=78&w=78&mode=stretch)


![Institute of Post Graduate Medical Education And Research - [IPGMER]](https://image-static.collegedunia.com/public/college_data/images/appImage/10560_SSKM_APP.jpg?h=111.44&w=263&mode=stretch)

![Nilratan Sircar Medical College & Hospital - [NRS]](https://image-static.collegedunia.com/public/college_data/images/appImage/1489063561cover.jpg?h=111.44&w=263&mode=stretch)

![West Bengal University of Health Sciences - [WBUHS]](https://image-static.collegedunia.com/public/college_data/images/appImage/26027_WBHUS_NEW.jpg?h=111.44&w=263&mode=stretch)

![KPC Medical College and Hospital - [KPCMC&H]](https://image-static.collegedunia.com/public/college_data/images/appImage/10610_KPCM_APP.jpg?h=111.44&w=263&mode=stretch)

![Calcutta National Medical College - [CNMC]](https://image-static.collegedunia.com/public/college_data/images/appImage/7564_CMC_New.jpg?h=111.44&w=263&mode=stretch)













.png?h=72&w=72&mode=stretch)



![Calcutta National Medical College - [CNMC]](https://image-static.collegedunia.com/public/college_data/images/logos/1408433462s1.png?h=72&w=72&mode=stretch)
![College of Medicine and Sagore Dutta Hospital - [CMSDH]](https://image-static.collegedunia.com/public/college_data/images/logos/1484131569logo.jpg?h=72&w=72&mode=stretch)


![Burdwan Medical College & Hospital - [BMC]](https://image-static.collegedunia.com/public/college_data/images/logos/1517657840logoedt.png?h=72&w=72&mode=stretch)
![Institute of Post Graduate Medical Education And Research - [IPGMER]](https://image-static.collegedunia.com/public/college_data/images/logos/1395300276Institute of Post Graduate Medical Education And Research.png?h=72&w=72&mode=stretch)


![Nilratan Sircar Medical College & Hospital - [NRS]](https://image-static.collegedunia.com/public/college_data/images/logos/1418032446logo.png?h=72&w=72&mode=stretch)
![Midnapore Medical College & Hospital - [MMC]](https://image-static.collegedunia.com/public/college_data/images/logos/1484138514logo.jpg?h=72&w=72&mode=stretch)
![Diamond Harbour Government Medical College & Hospital - [DHGMCH]](https://image-static.collegedunia.com/public/college_data/images/logos/1591611469DiamondHarbourGovernmentMedicalCollegeandHospitalLogo.png?h=72&w=72&mode=stretch)

![North Bengal Medical College - [NBMC]](https://image-static.collegedunia.com/public/college_data/images/logos/148491268410797logo.jpeg?h=72&w=72&mode=stretch)
![KPC Medical College and Hospital - [KPCMC&H]](https://image-static.collegedunia.com/public/college_data/images/logos/1561719376logo20.png?h=72&w=72&mode=stretch)
![ESI Post Graduate Institute of Medical Science and Research - [PGIMSR]](https://image-static.collegedunia.com/public/college_data/images/logos/148491248610417logo.jpeg?h=72&w=72&mode=stretch)




Comments
Found 12 Comments
RG Kar Medical College and Hospital in Kolkata is a government medical college affiliated with the West Bengal University of Health Sciences. Admissions to the MBBS program are conducted through the National Eligibility cum Entrance Test (NEET) and are based on merit. The college does not have a management quota for MBBS admission. The total number of MBBS seats at RG Kar Medical College is 250. Fifteen percent of these seats are allotted through the All India Quota, while the remaining eighty-five percent are filled through the West Bengal State Quota via the West Bengal Medical Counseling Committee (WBMCC).
WB JENPAS UG 2025 Exam Date has been announced by West Bengal Joint Entrance Examinations Board (WBJEEB) for admission to B.Sc Nursing & Paramedical UG Courses. The exam will be held on May 25, 2025 (Tentatively). The start date for the online application will be announced soon on the official website @wbjeeb.nic.in/jenpas-ug
R G Kar Medical College and Hospital in Kolkata is a government medical college. It is one of the oldest medical colleges in India and is affiliated with the West Bengal University of Health Sciences. The college is fully funded and managed by the Government of West Bengal.
RGKMCH has not released the fee structure of B.Sc. Nursing in online mode.
RGKMCH has not released the fee structure of B.Sc. Nursing in online mode.
Admissions have been concluded for the academic year 2023-24 at the R G Kar Medical College.
You can check out Cutoff ranks or marks for your desired course at RGKMCH Kolkata at the mentioned link. Visit: RGKMCH Cutoff
The cut-off for MBBS in NEET at RGKMCH Kolkata was 42976.
For admission to RGKMCH Kolkata, you need to appear for NEET entrance exam only.
Dear candidate, you can check out the cut-off for MBBS at RG Kar Medical College Kolkata Cut-off.
The documents which are required at the time of admission to MBBS in RK Kar Medical College and Hospital are mentioned below:
RGKMCH is a private college which has been affiliated with WBUHS Kolkata. The college has also been approved by the Medical Council of India.